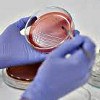

Запись
510₽
+7(495 ..показать +7(499) 11-68-239+7(495) 407-03-65
СМ-Клиника на Сенежской Москва; ул. Сенежская, д. 1/9 ; м. Речной Вокзал
Запись
800₽
+7(831 ..показать +7(499) 11-68-239+7(831) 462-05-00 +7(999) 072-34-08
МЦ Ника на Воровского Нижний Новгород; ул. Воровского, д. 3 ; м. Горьковская
Запись
1020₽
+7(499 ..показать +7(499) 11-68-239
СМ-Клиника на Маршала Захарова Санкт-Петербург; ул. Маршала Захарова, д. 20 ; м. Ленинский проспект
Запись
1020₽
+7(499 ..показать +7(499) 11-68-239
СМ-Клиника на Малой Балканской Санкт-Петербург; ул. Малая Балканская, д. 23 ; м. Купчино
Запись
1020₽
+7(499 ..показать +7(499) 11-68-239
СМ-Клиника на проспекте Ударников Санкт-Петербург; пр-т Ударников, д. 19 ; м. Ладожская
Запись
1200₽
+7(863 ..показать +7(499) 11-68-239+7(863) 308-93-03 +7(863) 310-83-43
Фабрика Здоровья на Ченцова Ростов-на-Дону; ул. Ченцова, д. 40 ;
Запись
1250₽
+7(383 ..показать +7(499) 11-68-239+7(383) 388-73-24
Клиника XXI век на Некрасова Новосибирск; ул. Некрасова, д. 35 ; м. Сибирская
Запись
1250₽
+7(383 ..показать +7(499) 11-68-239+7(383) 388-73-24
Клиника XXI век на Выборной Новосибирск; ул. Выборная, д. 89/2 ; м. Золотая нива
Запись
1250₽
+7(812 ..показать +7(499) 11-68-239+7(812) 561-45-68
XXI век на Большом Сампсониевском проспекте Санкт-Петербург; Большой Сампсониевский пр-т, д. 45 ; м. Выборгская
Запись
1270₽
+7(499 ..показать +7(499) 11-68-239+7(499) 519-37-34 +7(495) 106-13-44
К+31 на Лобачевского Москва; ул. Лобачевского, д. 42, стр. 4 ; м. Проспект Вернадского
Запись
1872₽
+7(383 ..показать +7(499) 11-68-239+7(383) 217-04-11
Аперто Диагностик на Красном проспекте Новосибирск; Красный пр-т, д. 54 ; м. Красный проспект
Запись
1880₽
+7(863 ..показать +7(499) 11-68-239+7(863) 310-57-77 +7(863) 310-67-77
МЦ Рождение на Варфоломеева Ростов-на-Дону; ул. Варфоломеева, д. 239 ;
Запись
1900₽
+7(495 ..показать +7(499) 11-68-239+7(495) 989-57-30
Олимп Клиник на Садовой-Сухаревской Москва; ул. Садовая-Сухаревская, д. 7/1 ; м. Цветной Бульвар
Запись
2400₽
+7(861 ..показать +7(499) 11-68-239+7(861) 205-00-08
Life на Восточно-Кругликовской Краснодар; ул. Восточно-Кругликовская, д. 30 ;
Запись
2800₽
+7(343 ..показать +7(499) 11-68-239+7(343) 270-17-17 +7(343) 364-11-25
МЦ Здоровье 365 на Кузнечной Екатеринбург; ул. Кузнечная, д. 83 ; м. Динамо
Запись
3390₽
+7(495 ..показать +7(499) 11-68-239+7(495) 331-85-10 +7(495) 331-16-01 +7(495) 331-85-10
Клинический Госпиталь MD GROUP на Севастопольском проспекте Москва; Севастопольский пр-т, д. 24, корп. 1 ; м. Профсоюзная
Запись
3615₽
+7(800 ..показать +7(499) 11-68-239+7(800) 700-70-01
Поликлиника КГ «Лапино» в Одинцово Одинцово; ул. Маршала Неделина, д. 15 ; м. Рассказовка
Запись
5876₽
+7(495 ..показать +7(499) 11-68-239+7(495) 781-55-77 +7(800) 302-55-77
GMS Clinic на 2-й Ямской Москва; ул. 2-я Ямская, д. 9 ; м. Марьина Роща
Запись
5876₽
+7(495 ..показать +7(499) 11-68-239+7(495) 781-55-77 +7(800) 302-55-77 +7(495) 104-86-05 +7(800) 775-42-74
GMS Hospital на Каланчевской Москва; ул. Каланчевская, д. 45 ; м. Комсомольская
Запись
5876₽
+7(495 ..показать +7(499) 11-68-239+7(495) 781-55-77 +7(800) 302-55-77
GMS Clinic в 1-м Николощеповском переулке Москва; 1-й Николощеповский пер., д. 6, стр. 1 ; м. Смоленская
Ещё клиник - 177 . Используйте фильтры